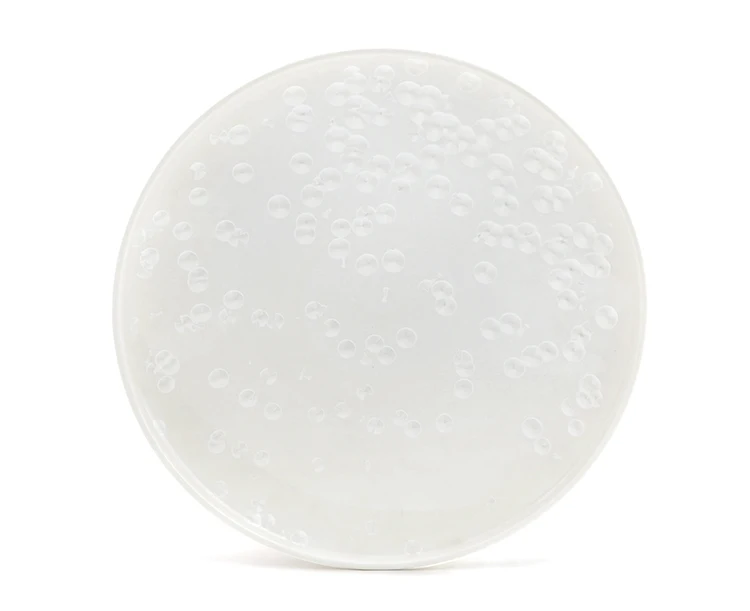

Please click the link to contact us for good price.

1. We currently accept Visa, Master Card and TT, e-checking( or the alibaba trade assurance)
2.All the products we will have 3 layers packing also by wooden pallet , Maximumly protect them before shipping.
3. The information you give us is for our secure database and is not given out, sold or bargained for by anyone else. The information is only used for our records, to better serve you.
4. All Dinnerware are SAFETY put in refrigerator, Dishwasher,Mirowave oven, disinfection cabinet, steamer.and the material all in the standard porcelain material , without any Hazardous chemical materials, also we have the test report for each item.
5.Our website uses up-to-date security measures on all of its pages. We use software that encrypts your private information while checking out. Your encrypted data is then sent to us through a Secure Socket Layer (SSL) security protocol. This form of submission is the industry standard for internet security. All information that you transmit to us through our website is completely private. We do not sell, trade or give away your information to any outside sources.


Ron Group specialize exclusively in the hospitality industry. Ron Group have extensive experience executing large commercial projects around the world.
Ron Group has more than 10000 products savings you up to 65% cost, and more than 75% of the products are in stock.
At Ron Group we are with you every step of the way, providing you end to end solutions including logistics and quality control. At Ron group we have successfully facilitated 4300+ satisfied customers to date in over 89 countries around the world including some of the world's larger restaurant groups to small boutique hotel brands.
Ron group have been involved in fit outs and refurbish and total construction of cafes, bars, restaurants, hotels, wedding & events end to end from design to continued logistical support with the supply of materials and associated stock from branded crockery to specialized custom equipment.
Ron group is not focused on the size of the next sale but about the future relationship it can create with its client partners. With long standing clients
Ron Group boasts continued business relationship with the same clients for more than 14 years.We look forward to create the same ongoing partnership with you.
Ron Group, the hospitality specialists you can trust.



Why choose us?
1. Your Restaurant, Hotel,Bar&Cafe, One-Stop Solution since 2005,With over 4500+ satisfied customers worldwide in over 88 countries.
2. More than 10000 products savings you up to 65%
3. Ron Group direct from over 350 manufacturers and brings you the best products at the best possible prices.
4.We can provide customers with high-quality products and service. We are committed to doing the very best for customers.
5.All the products are in conformity with LFGB regulations.
6.We have passed GMP audit.
7.We have the ability to research and create new designed products continuously to stay ahead in the industry.
What are the advantages of Ron Group?
1. Save more than 65% cost.
2. More than 75% product have stock.
3. Professional design and custom-made products.
4. 14+ Years restaurant overall supporting experience.
5. 89 cooperative countries.
6. 4300+ client
7. Minimum MOQ
8. Form Factory direct to customer.
9. China No.1 company can ensure lifetime warranty on any lip edge chip.
Are samples free?
We are pleased to provide free samples, while courier shipping costs for customers' account.
Any special requirements need to be negotiated with us.
Do you offer custom packaging?
Yes, we are able to provide custom packaging, like printed bag, color box etc.
What is the standard production time for each order?
Usually, the production time for each order is around 28 days, but the actual time
will be subject to the order quantity, packaging way and busy season etc.
What is your lead time and cost for samples?
For existing samples, they are free of charge and we usually get them ready in 7 days. For customized samples, the cost and sampling time will be up to the requirements.
For all the samples, we will send them freight collect. If you do not have a courier account, we can send them using our account after receiving the payment via PayPal.
What countries do you export to?
USA, Canada, UK, Australia,New Zealand ARGENTINA,BRAZIL,CHILE, Germany, France,UK,Italy, Lebanon, Qatar,Russian,Saudi Arabia,Sweden,South Africa, Canada, UK, Australia,New Zealand, Israel, ect 89 country




Sylvia Liang-Ron Group
86-18098163178
sales19@rongroup.co